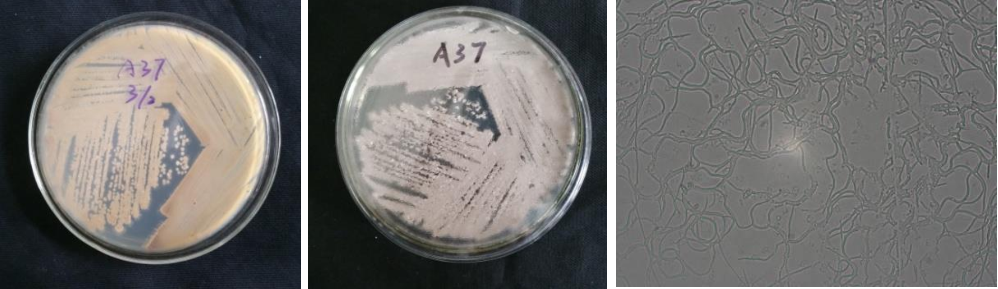

Loading...
| StrainNO | A37 |
| Classification | Actinomyces |
| 16s rDNA sequence | CCTTATCCGCTTGCGGGTTTGGTGAGAGTGGCGAACGGGTGAGTAACACGTGAGTAACCTGCCCCCTTCTTTGGGATAACTGCCG GAAACGGTGGCTAATACTGGATATTCAGCACTGGTCGCATGGTTGGTGTTGGAAAGGTTTTTCTGGTGGGGGATGGGCTCGCGGC CTATCAGCTTGTTGGTGGGGTGATGGCCTACCAAGGCTTTGACGGGTAGCCGGCCTGAGAGGGTGACCGGCCACACTGGGACTGA GACACGGCCCAGACTCCTACGGGAGGCAGCAGTGGGGAATATTGCACAATGGGGGAAACCCTGATGCAGCGACGCCGCGTGAGGG ATGACGGCCTTCGGGTTGTAAACCTCTTTCAGTAGGGAAGAATTTAGACGGTACCTGCAGAAGAAGCGCCGGCTAACTACGTGCC AGCAGCCGCGGTAATACGTAGGGCGCAAGCGTTGTCCGGAATTATTGGGCGTAAAGAGCTCGTAGGCGGCTTGTCGCGTCTGTCG TGAAAACCTGCAGCTTAACTGTGGGCTTGCGGTGGGTACGGGCTGGCTTGAGTGCAGTAGGGGAGACTGGAATTCCTGGTGTAGC GGTGGAATGCGCAGATATCAGGAGGAACACCGGTGGCGAAGGCGGGTCTCTGGGCTGTTACTGACGCTGAGGAGCGAAAGCATGG GGAGCGAACAGGATTAGATACCCTGGTAGTCCATGCCGTAAACGTTGGGCACTAGGTGTGGGGACCAGTTCCATGGTTTCTGTGC CGTAGCTAACGCATTAAGTGCCCCGCCTGGGGAGTACGGCCGCAAGGCTAAAACTCAAAGGAATTGACGGGGGCCCGCACAAGCG GCGGAGCATGCGGATTAATTCGATGCAACGCGAAGAACCTTACCAAGGCTTGACATACACCGGAATGCTGCAGAGATGTGGCAGC CTTTGGGCTGGTGTACAGGTGGTGCATGGTTGTCGTCAGCTCGTGTCGTGAGATGTTGGGTTAAGTCCCGCAACGAGCGCAACCC TTGTCTCATGTTGCCAGCACGTGATGGTGGGGACTCATGAGAGACTGCCGGGGTTAACTCGGAGGAAGGTGGGGATGACGTCAAA TCATCATGCCCCTTATGTCTTGGGCTTCACGCATGCTACAATGGCCGGTACAGTGGGTTGCGATCTCGTGAGGGGGAGCTAATCC TTGAAAGCCGGTCTCAGTTCGGATTGGGGTCTGCAACTCGACCCCATGAAGTCGGAGTCGCTAGTAATCGCAGATCAGCAACGCT GCGGTGAATACGTTCTCGGGCCTTGTACACACCGCCCGTCACGTCACGAAAGTTGGTAACACCCGAAGCTCATGGCCTAACCCTT TGGGGGGGAGTGGTCGAAGGTGGGACTGGCGATTGGGACGAAGTCGTAACAAGGTAGCCGTACCGG |
| Strain Morphology Photos | |
| Morphological Description | The morphology of strain:Grow weak;The spore heap is gray;back is earthy;earthy smell is big |